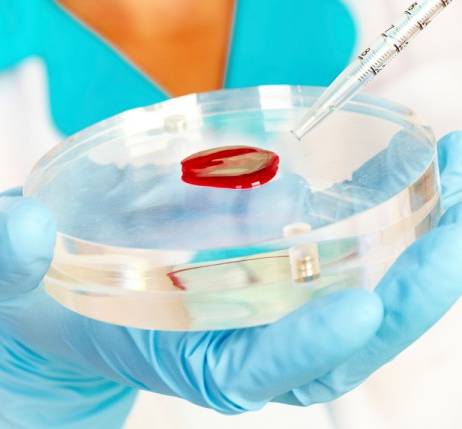

뉴스
2020년 01월 31일 인기기사


- 신종 코로나 현재 확진환자 총 11명
- 신종 코로나바이러스 감염증에 대한 확진자가 현재 총 11명으로 집계됐다. 질병관리본부 중앙방역대책본부(본부장 정은경)는 5~7번...
- 이승덕 기자 공감0 | 비공감0
2020-01-31 15:07

- 신종 코로나 7번째 확진자 확인…서울의료원 격리
- 질병관리본부 중앙방역대책본부(본부장 정은경)는 추가 환자 1명(7번째 환자)을 확인했다고 밝혔다. 7번째 확진환자(28세 남자, 한국인)는 중국 우한에서 청도...
- 이승덕 기자 공감0 | 비공감0
2020-01-31 09:47


- 이의경 식약처장, 보건용마스크 유통 점검차 'LG생활건강' 방문
- 식품의약품안전처 이의경 처장은 1월 31일 마스크가 제조되어 소비자에게 최종 전달되기 전까지 공급이 원활히 이뤄지고 있는지...
- 김용주 기자 공감0 | 비공감0
2020-01-31 09:28

- 로슈, 신종 코로나바이러스에 자체 진단 테스트 도입
- 세계보건기구(WHO)가 중국 우한에서 발생한 신종 코로나바이러스 사태를 국제 공중 보건 비상 사태로 선포한 가운데, 로슈가 이를 진...
- 전세미 기자 공감0 | 비공감0
2020-01-31 11:07

- 트루리시티·엑티라제 분당서울대병원 입성
- (31일 2)당뇨병치료제 ‘트루리시티펜’과 혈전용해제 ‘엑리타제주사’가 분당서울대병원 처방리스트에 새롭게 이름을 올렸다. 분당서울대병원은 최근 열린 약사위원회...
- 김정일 기자 공감0 | 비공감0
2020-01-31 06:00
오늘의 헤드라인
-
01 한국유니온제약 상폐 수순…정리매매 돌입 속... -
02 "공정 불순물 관리 핵심 ‘HCP’ 분석·제어 전... -
03 에피바이오텍, 동종 모유두세포 치료제 핵심... -
04 트럼프,의약품 관세 부과...한국산 의약품 1... -
05 큐라클, CU01 당뇨병성 신증 임상2b상 효능·... -
06 LG화학, 모치다제약 자궁내막증 치료제 ‘디... -
07 [2026 기대 신약 TOP 10] ② 비만 치료제 '올... -
08 [영상] KOREA PACK & ICPI WEEK 2026, 제조 ... -
09 깐깐해지는 의약품 제조 규제… 제약 제조 혁... -
10 [최기자의 약업위키] 자궁내막암 면역항암제...







